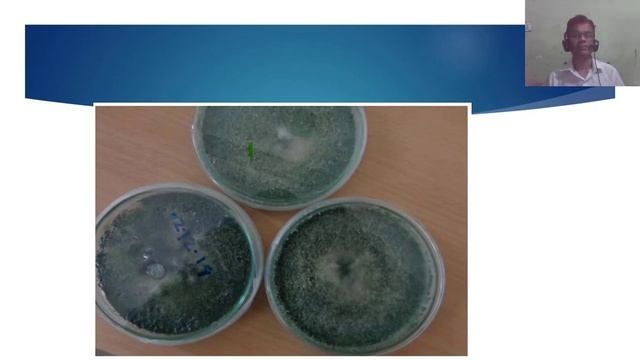
ট্রাইকোডার্মা উৎপাদন পদ্ধতি ( Production Technology Of Trichoderma)

Лесные импровизации - Новые видео
-
-
АНАРХИЯ ИГРАЕМ НА HOLYWORLDE!
IP- mc.HolyWorld.ru (1.16.5) 💸 Отправить донат – https://www.donationalerts.com/r/flaeryt 💸 Отправить донат из Украины – https://new.donatepay.ru/@9951...
Смотреть -
Mi Történik, Ha Nem Rendeltetésszerűen Fogyasztjuk A DXN Egészséges Kávékat? (Cordyceps Coffee 3in1
Sajnáld másoktól a gombáskávédat, ne adj belőle senkinek! 😊 https://www.kavekiraly.hu/cordyceps-sinensis-kinai-hernyogomba-a-himalaja-viagraja/ Miért dr...
Смотреть -
Невероятно Вкусные Овощи по бенгальски, с кунжутными семечками, обжареные в соевом соусе! За 20 мин
Не знаете что приготовить из овощей? Приготовьте удивительное блюдо индийской кухни-сабджи! Зачастую это блюдо сравнивают с привычным нам рагу) но спосо...
Смотреть -
Grzyby 2021 Tak Było We Wrześniu Część 3
Witam wszystkich! Przedstawiam państwu serię filmów z bardzo obfitych grzybobrań, które miały miejsce w Beskidzie Niskim we wrześniu. Filmy te miały być...
Смотреть -
-
ACTIVISION, фиксаните молотов
Толян поймал горячего, от безнадёги я даже и не думал о стрельбе-скорее в голове крутился план пожарной безопасности и местоположение огнетушителей( C...
Смотреть -
-
-
Come Conservare Perfettamente I Funghi Secchi [sub Eng]
Cari amici vi propongo un metodo sicuro per poter conservare i vostri funghi secchi a lungo nel tempo, seguite tutto il video e avrete grandi risultati....
Смотреть -
Доктор Рэй Стрэнд рекомендует
Понравилось - свяжитесь со мной по тел. +7-926-229-40-11 купите сами http://newage.com/N5038484
Смотреть -
-
ট্রাইকোডার্মা উৎপাদন পদ্ধতি ( Production Technology Of Trichoderma)
#Tricho- compost #Tricho-powder# Tricho-suspension Characteristics of Trichoderma
Смотреть -
-
Homemade Coconut Truffles | The Sweet Art Food Studio | #homemade #chocolate #coconut #truffle
#HomemadeCoconutTruffles #DecadentDelights #CoconutGoodness #HomemadeGoodness #SweetTreat #GiftFromTheHeart #HomemadeElegance #DessertDelights #SweetInd...
Смотреть -
Стрим: Бог устал нас любить - Заканчиваем с настройками и стартуем!
#3_to_play #симс4 #sims4 . Ссылка на донаты: https://www.donationalerts.com/r/3_to_play . Ссылка на группу Вконтакте: https://vk.com/3toplay . Правила...
Смотреть -
MycoSymbiotics Cordyceps Mushroom Cultivation Growing DIY Fungi Farm Pt 2 Mycology At Its Finest! Y
North American Cordyceps Farms Now & Tomorrow This video is Part 2 of 3 presented by William Padilla-Brown at the 2017 Telluride Mushroom Festival. ...
Смотреть -
My Edited Video
Это видео создано с помощью видеоредактора YouTube (http://www.youtube.com/editor)
Смотреть -
Разговоры на кухне 💥 Будни домохозяйки из Сочи 🌴
моя жизнь как она есть #лайфстайл #блогершакофеманка #домашнийвлог #жизньпрекрасна #блог #болталка #разговорынакухне #реальнаяжизнь #готовимвместе #утре...
Смотреть -
THE GUSHERS CAKE DIY! - How To Make Gushers Candy Filled Cake
THE GUSHERS CAKE DIY! - How To Make Gushers Candy Filled Cake this is how to make an amazing fruit gushers candy cake! this diy dessert is so delicious...
Смотреть









![Come Conservare Perfettamente I Funghi Secchi [sub Eng]](https://pic.rtbcdn.ru/video/2025-02-03/08/3e/083e5b8c99f6ae06e5d11c3e5fa0e188.jpg)